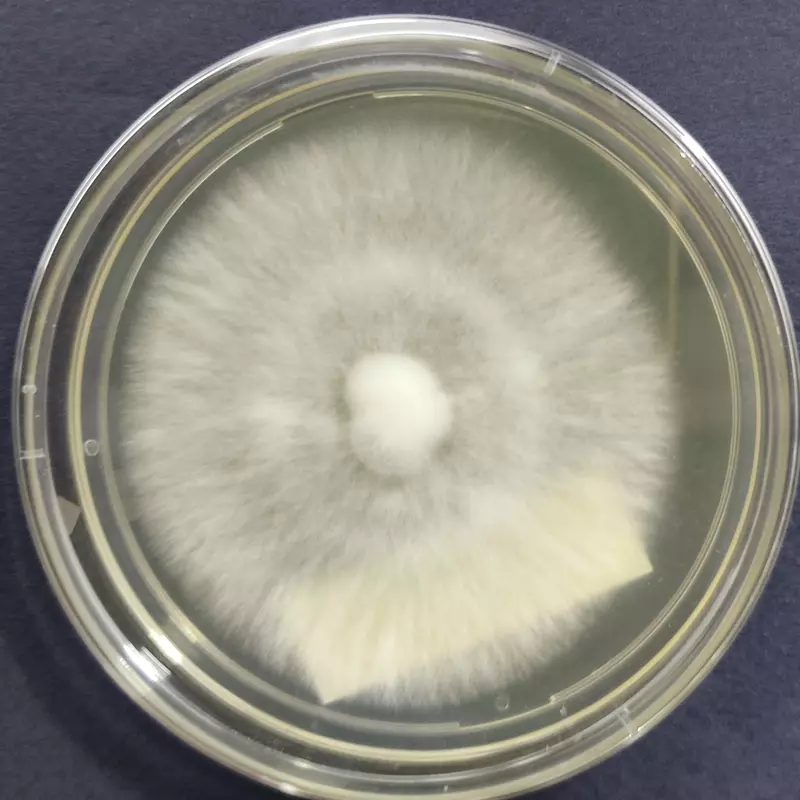

Calocybe indica (Milky Mushroom) โ Pure Culture Plate
High-performance Calocybe indica (Milky Mushroom) pure culture plate for commercial tropical cultivation and research use. Renowned for its large white fruit bodies, high yield, and heat tolerance, this strain is ideal for mushroom farms and training centers in warm climates.
๐ Proudly prepared and stored at Agripie Agrosystem LLP, India ๐ฎ๐ณ
The Calocybe indica (Milky Mushroom) โ Pure Culture Plate provides a verified, contamination-free strain of Indiaโs leading tropical edible mushroom.
Popular for its robust growth, excellent texture, and nutritional value, Milky Mushroom is a high-yield species suitable for year-round cultivation in warm and humid regions.
This culture ensures vigorous mycelial growth, fast substrate colonization, and excellent shelf life of fruit bodies. Ideal for spawn laboratories, commercial cultivators, and research institutions, it performs exceptionally well on pasteurized paddy straw, compost, or agro-waste substrates.
Features:
Authentic Calocybe indica strain (Milky Mushroom)
Fast-growing, heat-tolerant tropical species
High biological efficiency and yield stability
Suitable for commercial and research cultivation
Large, firm, white fruit bodies with long storage life
100% pure and contamination-free culture
๐ Proudly prepared and stored at Agripie Agrosystem LLP, India ๐ฎ๐ณ

|
| 
